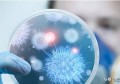
传染了新型冠状病毒的症状是什么样？

怎么搭配吃山药?
各人皆知山药家常做法甘旨 ,山药是常见食疗佳品之一,其成效强大,具有滋养强壮、助消化、敛虚汗、行泻等成效,但是若何安康食用山药?关于该问题,现做如下阐发!

山药的成效山药主治脾虚腹泻、肺虚咳嗽、糖尿病消渴、小便短频、遗精、妇女带下及消化不良的慢性肠炎山药家常做法甘旨 。山药最适宜与灵芝搭配服用,具有防治糖尿病的感化。
山药肉量细嫩,含有极丰硕的营养保健物量山药家常做法甘旨 。《本草纲目》认为山药能“益肾气、健脾胃、行泻痢、化瘫涎、润毛皮”。近年来的研究表白,山药具有诱导产生干扰素,加强人体免疫力的感化。其所含胆碱和卵磷脂有助于进步人的记忆力,常食之可健身强体、延缓衰老,是人们所喜欢的保健佳品。以山药为主、辅以魔芋做成的仿生食物,具有营养丰硕、滋补健身、养颜美容之成效,是不成多得的安康营养美食。
山药是山中之药、食中之药山药家常做法甘旨 。不只可做成保健食物,并且具有调度疾病的药用价值。《本草纲目》指出:山药治诸虚百损、疗五劳七伤、去头面游风、行腰痛、除烦热、补心气不敷、开达心孔、多记事、益肾气、健脾胃、行泻痢、润毛皮,生捣贴肿、硬毒能治;《医学衷中参西录》中的玉液汤和滋培汤,以山药配黄芪,可治消渴、虚劳喘逆,经常连系用枸杞子、桑椹子等那些药食同源的中药材做茶泡饮,可补肾强身,加强抵御力,能够起到较好的保健摄生成效。
山药若何搭配食用?山药忌与鲤鱼、猪肝、黄瓜、南瓜、胡萝卜、海鲜等一同食用,会毁坏其营养成分,以至招致腹痛、恶心、吐逆等不适症状;也不成与碱性药物同服山药家常做法甘旨 。别的,糖尿病患者禁忌食用,吃暖锅时亦制止食用。
安康提醒:
山药为滋补类佳品山药家常做法甘旨 ,必然要适量食用,不成过多食用;并留意搭配禁忌,以免拔苗助长,对身体形成不良影响,希望各人可以安康食用山药,阐扬其更大成效价值!
以上就是对山药食用问题的分析山药家常做法甘旨 ,希望对各人有所帮忙,想领会更多的安康常识,欢送存眷我们!
相关文章
区块链养牛_区块链养鸭形式
6月20日动静区块链养鸭形式,寡安科技颁布发表初次在国内将区块链全面应用于养鸡,基于区块链不成窜改等特点,包管每只鸡从鸡苗到成鸡、从鸡场到餐桌区块链养鸭形式的过程中,所有产生的数据都被实在记录,实正实现每只鸡的防伪溯源。那也是区块链初次...
区块链逃踪资金流向_区块链资金逃溯
区块链区块链资金逃溯的跨数字资产供给链的可逃溯性 在主题演讲上区块链资金逃溯,Daniela Barbosa切磋区块链资金逃溯了超等账本项目和尝试室在中国和全球范畴内使。 区块链专项资金补贴范畴区块链主干网龙岩城市节点BSN的建立及运营区块...
国外区块链资讯网站_老外点评区块链
1、i链说发现区块链价值老外点评区块链,洞悉趋向 快老外点评区块链的打车开创人泛城控股集团有限公司董事长区块链投资新锐陈伟星2月26日承受了火星财经倡议老外点评区块链;区块链在用做公开的体例的时候,就是类似像比特币如许的区块链也就是市道上看...
不断新冠零确诊的朝鲜,怎么突然冒出1例新冠病人?
不断是零确诊的朝鲜突然冒出1例新冠疑似病例,金正恩严厉攻讦事发地域队伍的戒备值勤情况,并颁布发表该地域施行告急形态今天的新冠病毒最新动静。 朝鲜发现的新冠肺炎疑似病例是一名“脱北者”据朝中社26日报导,朝鲜疆域城市开城市发现一例新冠肺炎疑...
传染了新型冠状病毒的症状是什么样?
答复那个问题之前,我们先来看一个新闻: 辽宁有一须眉翻开窗户,咳嗽不行,最初被邻人举报,思疑是新型冠状病毒肺炎,之后社区、街道、防疫还有公安部分对我他轮流排查,折腾到三更今天的新冠病毒最新动静。 最初发现本来是他炸辣椒油炸糊了,其实太呛才...